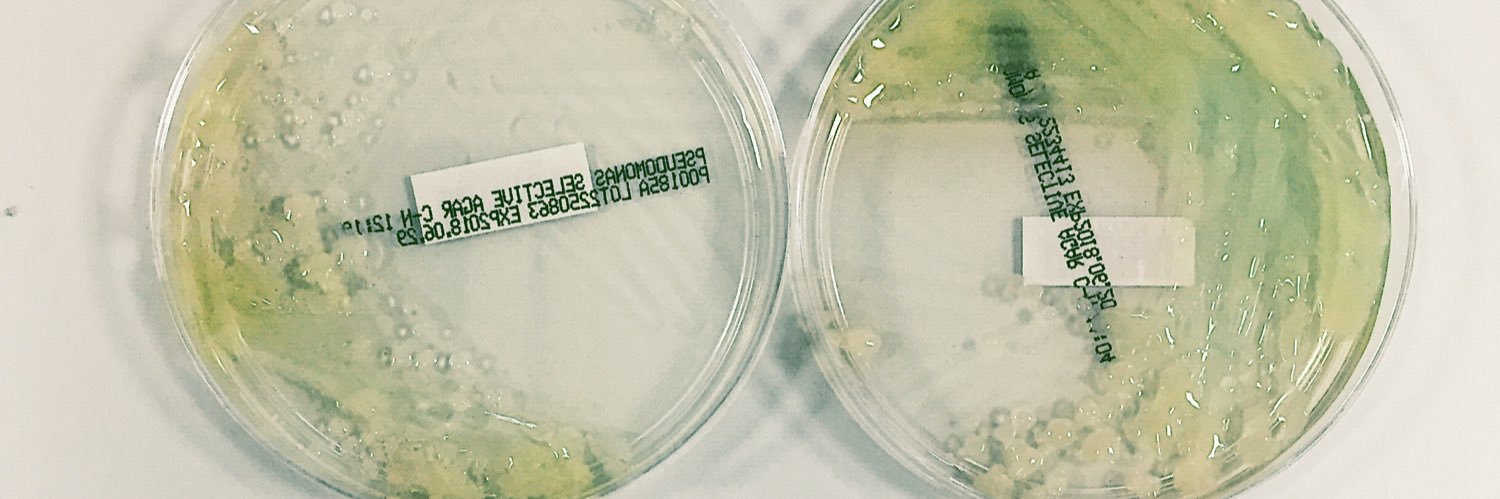
Ronan A. Murphy PhD banner

Ronan A. Murphy PhD
247 posts

Ronan A. Murphy PhD
@Mic_Ro_
Irish in Berlin. Microbiologist. Post-doc in Rolff Lab, Freie Universität Berlin. #AMR #AMPs. PhD from @ImperialNHLI Davies Lab. he/him



Hot off the press in @npjAMR @Mic_Ro_ et al., show the mechanism of action of antimicrobial peptide glatiramer acetate in Pseudomonas aeruginosa🦠💊 nature.com/articles/s4425… (1/6)



🚨Research Technician Opportunity Come and join the team of @janedaviescf to work on #Microbiology #Pseudomonas #CF #AMR @ImperialNHLI @ImperialMed Apply by the 1st Great boss and team! Please RT jobs.ac.uk/job/CZZ275/res…










Synergistic Activity of Repurposed Peptide Drug Glatiramer Acetate with Tobramycin Against Cystic Fibrosis Pseudomonas aeruginosa biorxiv.org/cgi/content/sh… #biorxiv_micrbio


